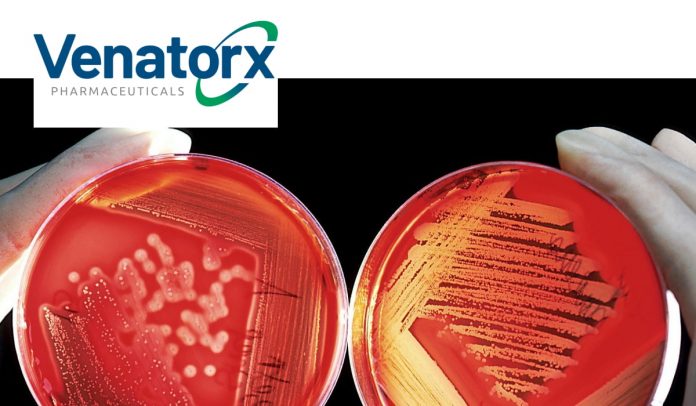
Venatorx

Venatorx Pharmaceuticals, Inc., a private, clinical-stage pharmaceutical company focused on improving health outcomes for patients with multidrug-resistant bacterial infections and hard-to-treat viral infections, on Monday announced that it sold shares of its Series C Preferred Stock in a financing led by the AMR Action Fund with participation from existing including Abingworth.
Proceeds from the financing will be used to support Venatorx as it advances its novel antibacterial portfolio through the drug development process, including a New Drug Application (NDA) with the U.S. Food and Drug Administration (FDA) for cefepime-taniborbactam for the treatment of complicated urinary tract infections (cUTI) in adult patients; continued advancement of cefepime-taniborbactam for patients with hospital-acquired bacterial pneumonia and ventilator-associated bacterial pneumonia; and further development of the Venatorx’s oral antibiotic, ceftibuten/VNRX-7145.
Christopher J. Burns, Ph.D., President and CEO of Venatorx, said:
This financing marks another significant milestone for Venatorx on the heels of announcing exciting positive topline Phase 3 data for our antibacterial program, cefepime-taniborbactam. Bringing the AMR Action Fund on board—with its consortium of global pharmaceutical companies, industry experts and coalitions—helps to further propel Venatorx forward and brings much needed capital back into the antibiotics space.
To date, in addition to equity financings, Venatorx has also received significant funding awards from: the National Institute of Allergy and Infectious Diseases of the National Institutes of Health; the Wellcome Trust; the Biomedical Advanced Research and Development Authority, part of the Office of the Assistant Secretary for Preparedness and Response at the U.S. Department of Health and Human Service; the U.S. Department of Defense’s Defense Threat Reduction Agency; as well as CARB-X. Venatorx also has license and/or collaboration agreements with Everest Medicines, Global Antibiotic Research and Development Partnership, and Roche.
Martin Heidecker, Ph.D., Chief Investment Officer at the AMR Action Fund, said:
Effective antibiotics are urgently needed to address the rapid rise of AMR. Our investment in Venatorx marks our first step towards bringing two to four new treatments to market by 2030 for priority pathogens identified by WHO and the CDC. Venatorx is focused on developing innovative antibacterial treatments that address the highest priority public health needs. We are inspired by Venatorx’s positive results from its Phase 3 clinical trial and believe that the company’s deep domain expertise and innovative portfolio positions it to make a significant difference in clinical practices and save lives.